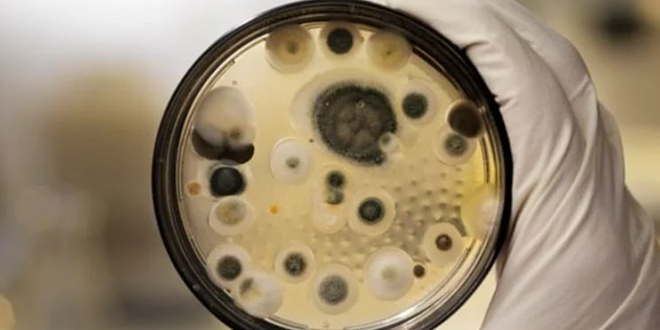

نجح باحثون من جامعة بنسلفانيا في تسخير فطر سام عُرف بارتباطه بـ”لعنة الفراعنة”، لإنتاج مركبات قوية قد تفتح آفاقاً جديدة في علاج السرطان، وتحديداً سرطان الدم.
ارتبط الفطر الذي يحمل اسم “Aspergillus flavus” (الرشاشيات الصفراء)، تاريخياً بسيناريوهات مأساوية وغامضة، أبرزها سلسلة الوفيات التي أعقبت فتح مقبرة الملك توت عنخ آمون عام 1922، وأخرى مشابهة في بولندا خلال سبعينيات القرن الماضي، عندما توفي 10 علماء عقب دخولهم مقبرة كازيمير الرابع. ووُجهت الشبهات حينها نحو هذا الفطر الذي يمكن لأبواغه، حتى بعد آلاف السنين، أن تُسبب التهابات رئوية قاتلة، خصوصاً لدى من يعانون من ضعف المناعة.
لكن ما كان يُعد “ميكروباً خبيثاً” في السابق، أصبح اليوم محور اكتشاف علمي واعد، بعد أن نجح الفريق البحثي بقيادة البروفيسورة شيري غاو في عزل فئة جديدة من الجزيئات النشطة بيولوجياً من هذا الفطر، أطلقوا عليها اسم “أسبيريجيميسين” (Aspergimisin).
ويُعد هذا الكشف امتداداً لنهج علمي قديم في استخلاص الأدوية من مصادر طبيعية، أشهرها البنسلين، الذي غيّر تاريخ الطب. وتقول غاو: “لقد وهبتنا الطبيعة صيدلية مذهلة، وعلينا أن نواصل كشف أسرارها”.
وتنتمي الجزيئات الجديدة التي تم اكتشافها إلى فئة نادرة تُعرف باسم “RiPPs”، وهي بروتينات تُنتَج أولاً عبر الريبوسومات، ثم تُعدّل لاحقاً لتحسين فاعليتها. وعلى الرغم من شيوع هذه الفئة في البكتيريا، فإن اكتشافها في الفطريات نادر وصعب، ما يجعل هذا الإنجاز العلمي فريداً من نوعه، وفقاً لموقع “إنتريستنغ إنجينيرينغ”.
عند اختبار “أسبيريجيميسين” على خلايا سرطان الدم، أظهرت بعض متغيراته تأثيراً قوياً حتى قبل التعديل. وبعد إدخال تعديل بسيط تمثل في إضافة جزيء دهني، وصل الأداء إلى مستوى مماثل لأدوية شهيرة ومعتمدة مثل السيتارابين والداونوروبيسين، واللذين يُستخدمان لعلاج سرطان الدم منذ عقود.
الاكتشاف لم يتوقف عند فاعلية الجزيئات، بل شمل أيضاً تحديد الآلية التي تدخل بها الخلايا السرطانية. فقد تم رصد جين يُعرف باسم SLC46A3، يعمل كـ”بوابة” تتيح دخول كميات كبيرة من هذه المركبات إلى داخل الخلايا الخبيثة، حيث تقوم بتعطيل عملية الانقسام الخلوي عبر استهداف الأنابيب الدقيقة اللازمة لتكاثر السرطان.
والمثير للاهتمام أن هذه الجزيئات لم تُظهر أي تأثير ضار على خلايا سرطانية أخرى مثل الثدي أو الكبد أو الرئة، كما لم تؤثر على البكتيريا والفطريات، ما يجعلها مرشحة مثالية لتطوير علاجات دقيقة ونوعية.
ويرى الفريق أن ما تم اكتشافه ما هو إلا بداية. فوفقاً للباحث تشيويو ني، فإن “الكنز الحقيقي يكمن في الفطريات الأخرى التي لم تُدرس بعد”، مضيفاً “على الرغم من العثور على عدد قليل فقط من RiPPs الفطرية، إلا أن معظمها يتمتع بنشاط حيوي قوي للغاية”.
ويشير هذا الاكتشاف إلى أن ما كان يعد “لعنة” في التاريخ، قد يتحوّل اليوم إلى هدية من الطبيعة في معركة البشرية ضد السرطان.
 مشاهد 24 موقع مغربي إخباري شامل يهتم بأخبار المغرب الكبير
مشاهد 24 موقع مغربي إخباري شامل يهتم بأخبار المغرب الكبير